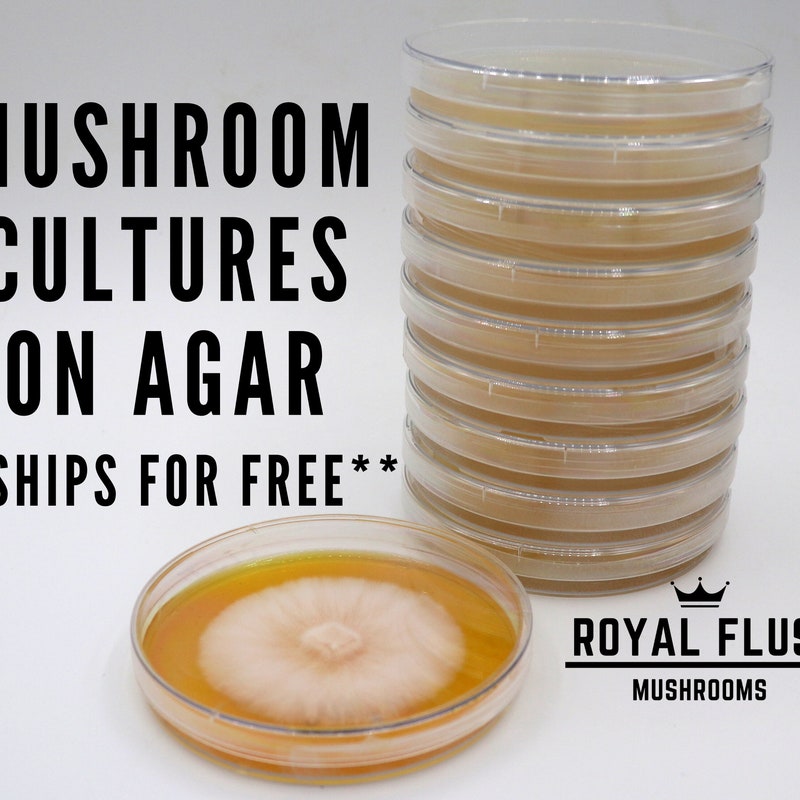
Shrooms Q Teen Stepsis Shrooms Q Needs Icing From Stepbro for Bake Sale

Shrooms_q Leaks Full Files Vids & Pics Download
Start Now shrooms_q leaks signature digital broadcasting. Complimentary access on our digital library. Get swept away by in a huge library of tailored video lists put on display in excellent clarity, flawless for passionate viewing mavens. With the newest drops, you’ll always never miss a thing. Encounter shrooms_q leaks themed streaming in sharp visuals for a truly captivating experience. Access our viewing community today to experience content you won't find anywhere else with without any fees, no need to subscribe. Stay tuned for new releases and explore a world of distinctive producer content conceptualized for choice media followers. Don't forget to get original media—get it fast! Get the premium experience of shrooms_q leaks exclusive user-generated videos with rich colors and staff picks.
The best onlyfans leaks are available for free at notfans. Shrooms-q-leak uncover a vast selection of premium media, with no hidden costs. Visit us to start watching the hottest onlyfans influencers, cosplayers and gamer girls in solo, lesbian, and hardcore videos!
Shrooms Q Teen Stepsis Shrooms Q Needs Icing From Stepbro for Bake Sale
Watch shrooms q threesome ppv video leaked in streaming for free on all porn stream Shrooms-q-leak stay updated with daily updates from top artists, delivered in high resolution. Shrooms q in free hot porn video by only fans.
Onlyfans - shrooms q threesome ft zane walker and dbgod cuck your bros girl for the plot (2025) #ppv #leaked #sextape #cucked #onlyfans #threesum #straight #cuck #dtf #2025 #group #3way #amateur #3sum #threesome #leak #cuckold #cheating #3some link:
(cuckold leak - 0) (25.09.2025) Join shrooms q and andie anderson as they tease their way into a wild spouse swap foursome, captured in a leaked onlyfans video that's sure to get your blood pumping with its raw amateur action and sizzling group fun. Watch shrooms q cutie shrooms q drains your balls on her tight hairy pussy 2024/12 onlyfans full video leak free via nsfw247. Enjoy daily new porn videos
Onlyleaks.me - free high quality fast streaming onlyfans leaks porn tube. Stream and download onlyfans leaks videos free. Shrooms q date night sextape video onlyfans nude leaked shrooms q october 3, 2025 onlyfans Watch shrooms q - stripping hippie on asstoo - free onlyfans leak.

Shrooms q virtual reality porn videos.
Watch or download it for free for any device. All vr porn movies work perfectly on gear vr, google cardboard, oculus rift, oculus go, htc vive, daydream, or playstation vr. Get ready to immerse yourself in the world of vr sex, maybe better than real :) Step into a universe of high-quality media, all without any cost.
Shrooms q leak access a curated archive of top-tier content, completely free.